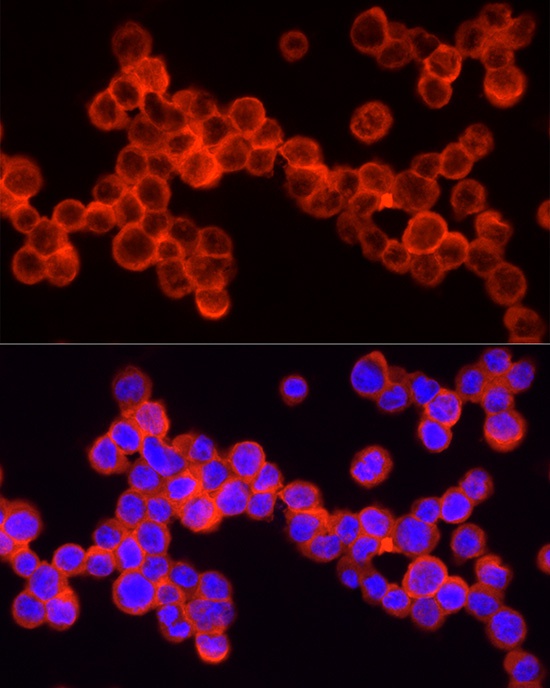
Product Image

Description
SHIP1 Antibody (CAB0122)
The SHIP1 Antibody (CAB0122) is a high-quality antibody developed for reliable detection and analysis of target proteins. INPP5D plays a crucial role in regulating immune cell signaling and is implicated in various immune-related diseases. This antibody is produced in rabbits and has been validated for use in Western blot applications, where it demonstrates high reactivity with human samples. By binding to the INPP5D protein, this antibody enables precise detection and analysis in a variety of cell types.
This antibody is validated for use in WB, IHC-P, IF/ICC, ELISA, IF-P applications and has demonstrated reactivity against Human, Mouse, Rat samples.
| Product Name: | SHIP1 Antibody |
| SKU: | CAB0122 |
| Size: | 20μL, 100μL |
| Reactivity: | Human, Mouse, Rat |
| Conjugate: | Unconjugated |
| Immunogen: | Synthetic peptide. This information is considered to be commercially sensitive. | ||||||||||
| Sequence: | PPCS GSSI TEII NPNY MGVG PFGP PMPL HVKQ TLSP DQQP TAWS YDQP PKDS PLGP CRGE SPPT PPGQ PPIS PKKF LPST ANRG LPPR TQES RPSD LGKN A | ||||||||||
| Tested Applications: | WB IHC-P IF/ICC ELISA IF-P | ||||||||||
| Recommended Dilution: |
| ||||||||||
| Synonyms: | SHIP, SHIP1, SHIP-1, hp51CN, SIP-145, p150Ship |
| Positive Sample: | Mouse spleen |
| Cellular Localization: | Cytoplasm, Membrane, Peripheral Membrane Protein. |
| Calculated MW: | 133kDa |
| Observed MW: | 140kDa |
This gene is a member of the inositol polyphosphate-5-phosphatase (INPP5) family and encodes a protein with an N-terminal SH2 domain, an inositol phosphatase domain, and two C-terminal protein interaction domains. Expression of this protein is restricted to hematopoietic cells where its movement from the cytosol to the plasma membrane is mediated by tyrosine phosphorylation. At the plasma membrane, the protein hydrolyzes the 5' phosphate from phosphatidylinositol (3,4,5)-trisphosphate and inositol-1,3,4,5-tetrakisphosphate, thereby affecting multiple signaling pathways. The protein is also partly localized to the nucleus, where it may be involved in nuclear inositol phosphate signaling processes. Overall, the protein functions as a negative regulator of myeloid cell proliferation and survival. Mutations in this gene are associated with defects and cancers of the immune system. Deficiencies in the encoded protein, SHIP1, have been associated with Inflammatory Bowel Disease types such as Crohn's Disease and Ulcerative Colitis. Alternative splicing of this gene results in multiple transcript variants.
| Purification Method | Affinity purification |
| Gene ID | 3635 |
| RRID | AB_2769979 |
| Buffer Information | Store at -20℃. Avoid freeze / thaw cycles. Buffer: PBS containing 50% glycerol, preserved with proclin300 or sodium azide, pH 7.3. |